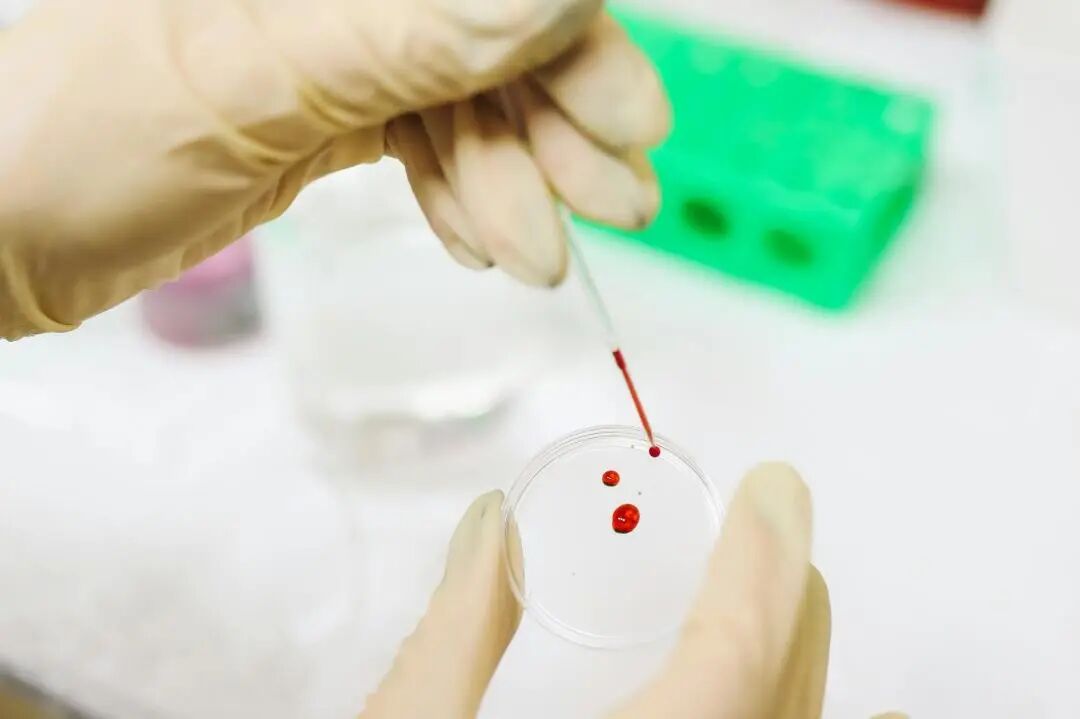

亲子鉴定多久出结果,可以快点吗?




图片来源:Pexels
整体来看,亲子鉴定的流程可以拆分为以下几个关键步骤:
1
选择正确的鉴定机构
一般可通过司法局官网或鉴定机构官网等渠道,选择具有相关资质,且声誉良好的司法亲子鉴定机构,也可以在诉讼过程中通过法院委托鉴定。
图片来源:Pexels
2
预约与咨询
许多机构提供在线预约服务,可以通过官方网站或电话咨询相关信息,了解所需的材料、流程,以及费用等。如果对亲子鉴定的技术和方式有疑虑,也可以向专业人员询问,帮助您更好地做出选择。
3
样本采集与分析
在预约成功后,被鉴定人需要亲自到指定地点进行样本采集。采样工作由鉴定机构工作人员进行,并在法医的见证下全程拍摄录影,以确保样本的准确性和安全性。
样本送检后,鉴定机构实验室会进行DNA检测,通常需要经过多个步骤,包括DNA提取、基因扩增和基因分型等。

图片来源:Pexels
4
实验室检测与鉴定意见书
司法亲子鉴定意见书,一般是在5至7个工作日内发出,如有特殊情况需要加急,可额外付费享受加急服务(最快可加急至6小时内出结果)。司法亲子鉴定意见书出具后,将由广州市司法鉴定业务管理系统签发,系统会将广州市司法局示证平台链接、统一案号、查询校验码以短信的形式,发送至鉴定委托人提前预留的手机号码上。届时,鉴定委托人只需要直接点击链接,即可查询司法亲子鉴定意见书。
在某些情况下,如果希望尽快获得亲子鉴定的结果,通常可以考虑以下两点:
1
选择加急服务
鉴定机构一般都会提供加急服务,可以在预约时询问相关费用和处理时间。加急处理一般可以将结果时间缩短至1-3个工作日,如果是当天早上9点左右做的鉴定,最快当天下午即可出具鉴定结果。
2
配合程度
在进行亲子鉴定时,确保与鉴定机构保持良好的沟通,在预约时间段内及时到达现场,提供所需的信息和材料,以便更快进入检验流程,可以加快鉴定的速度。
综上所述,亲子鉴定这项科学技术,可以帮助人们迅速且准确地判定亲子关系。提前了解相关流程和加急服务,可以帮助您更快速有效地获得结果。
END

暨南大学司法鉴定中心公众号
司法鉴定咨询/预约电话:
18011833065(微信同号)

暨南大学司法鉴定中心服务号
亲子鉴定 指纹鉴定 验伤/评残
死因鉴定 医疗损害 民事行为能力

